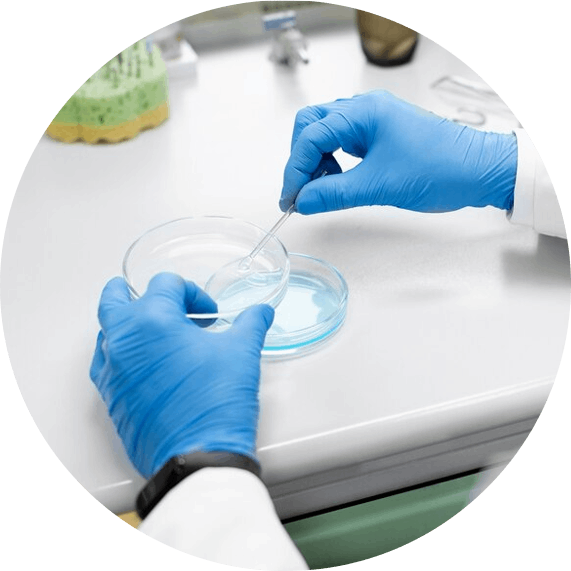

$2,000 monthly
$250 hourly

Personalized weight loss plans designed to fit your unique health..

Initial Consultation: In-depth health assessment and personalized...

Explore our curated selection of nutrients, supplements...

Experience with multiple accrediting agencies including
Email:
Phone:
Location:
Unit 6, 50 Berry Street, Nowra NSW, 2541, Australia
